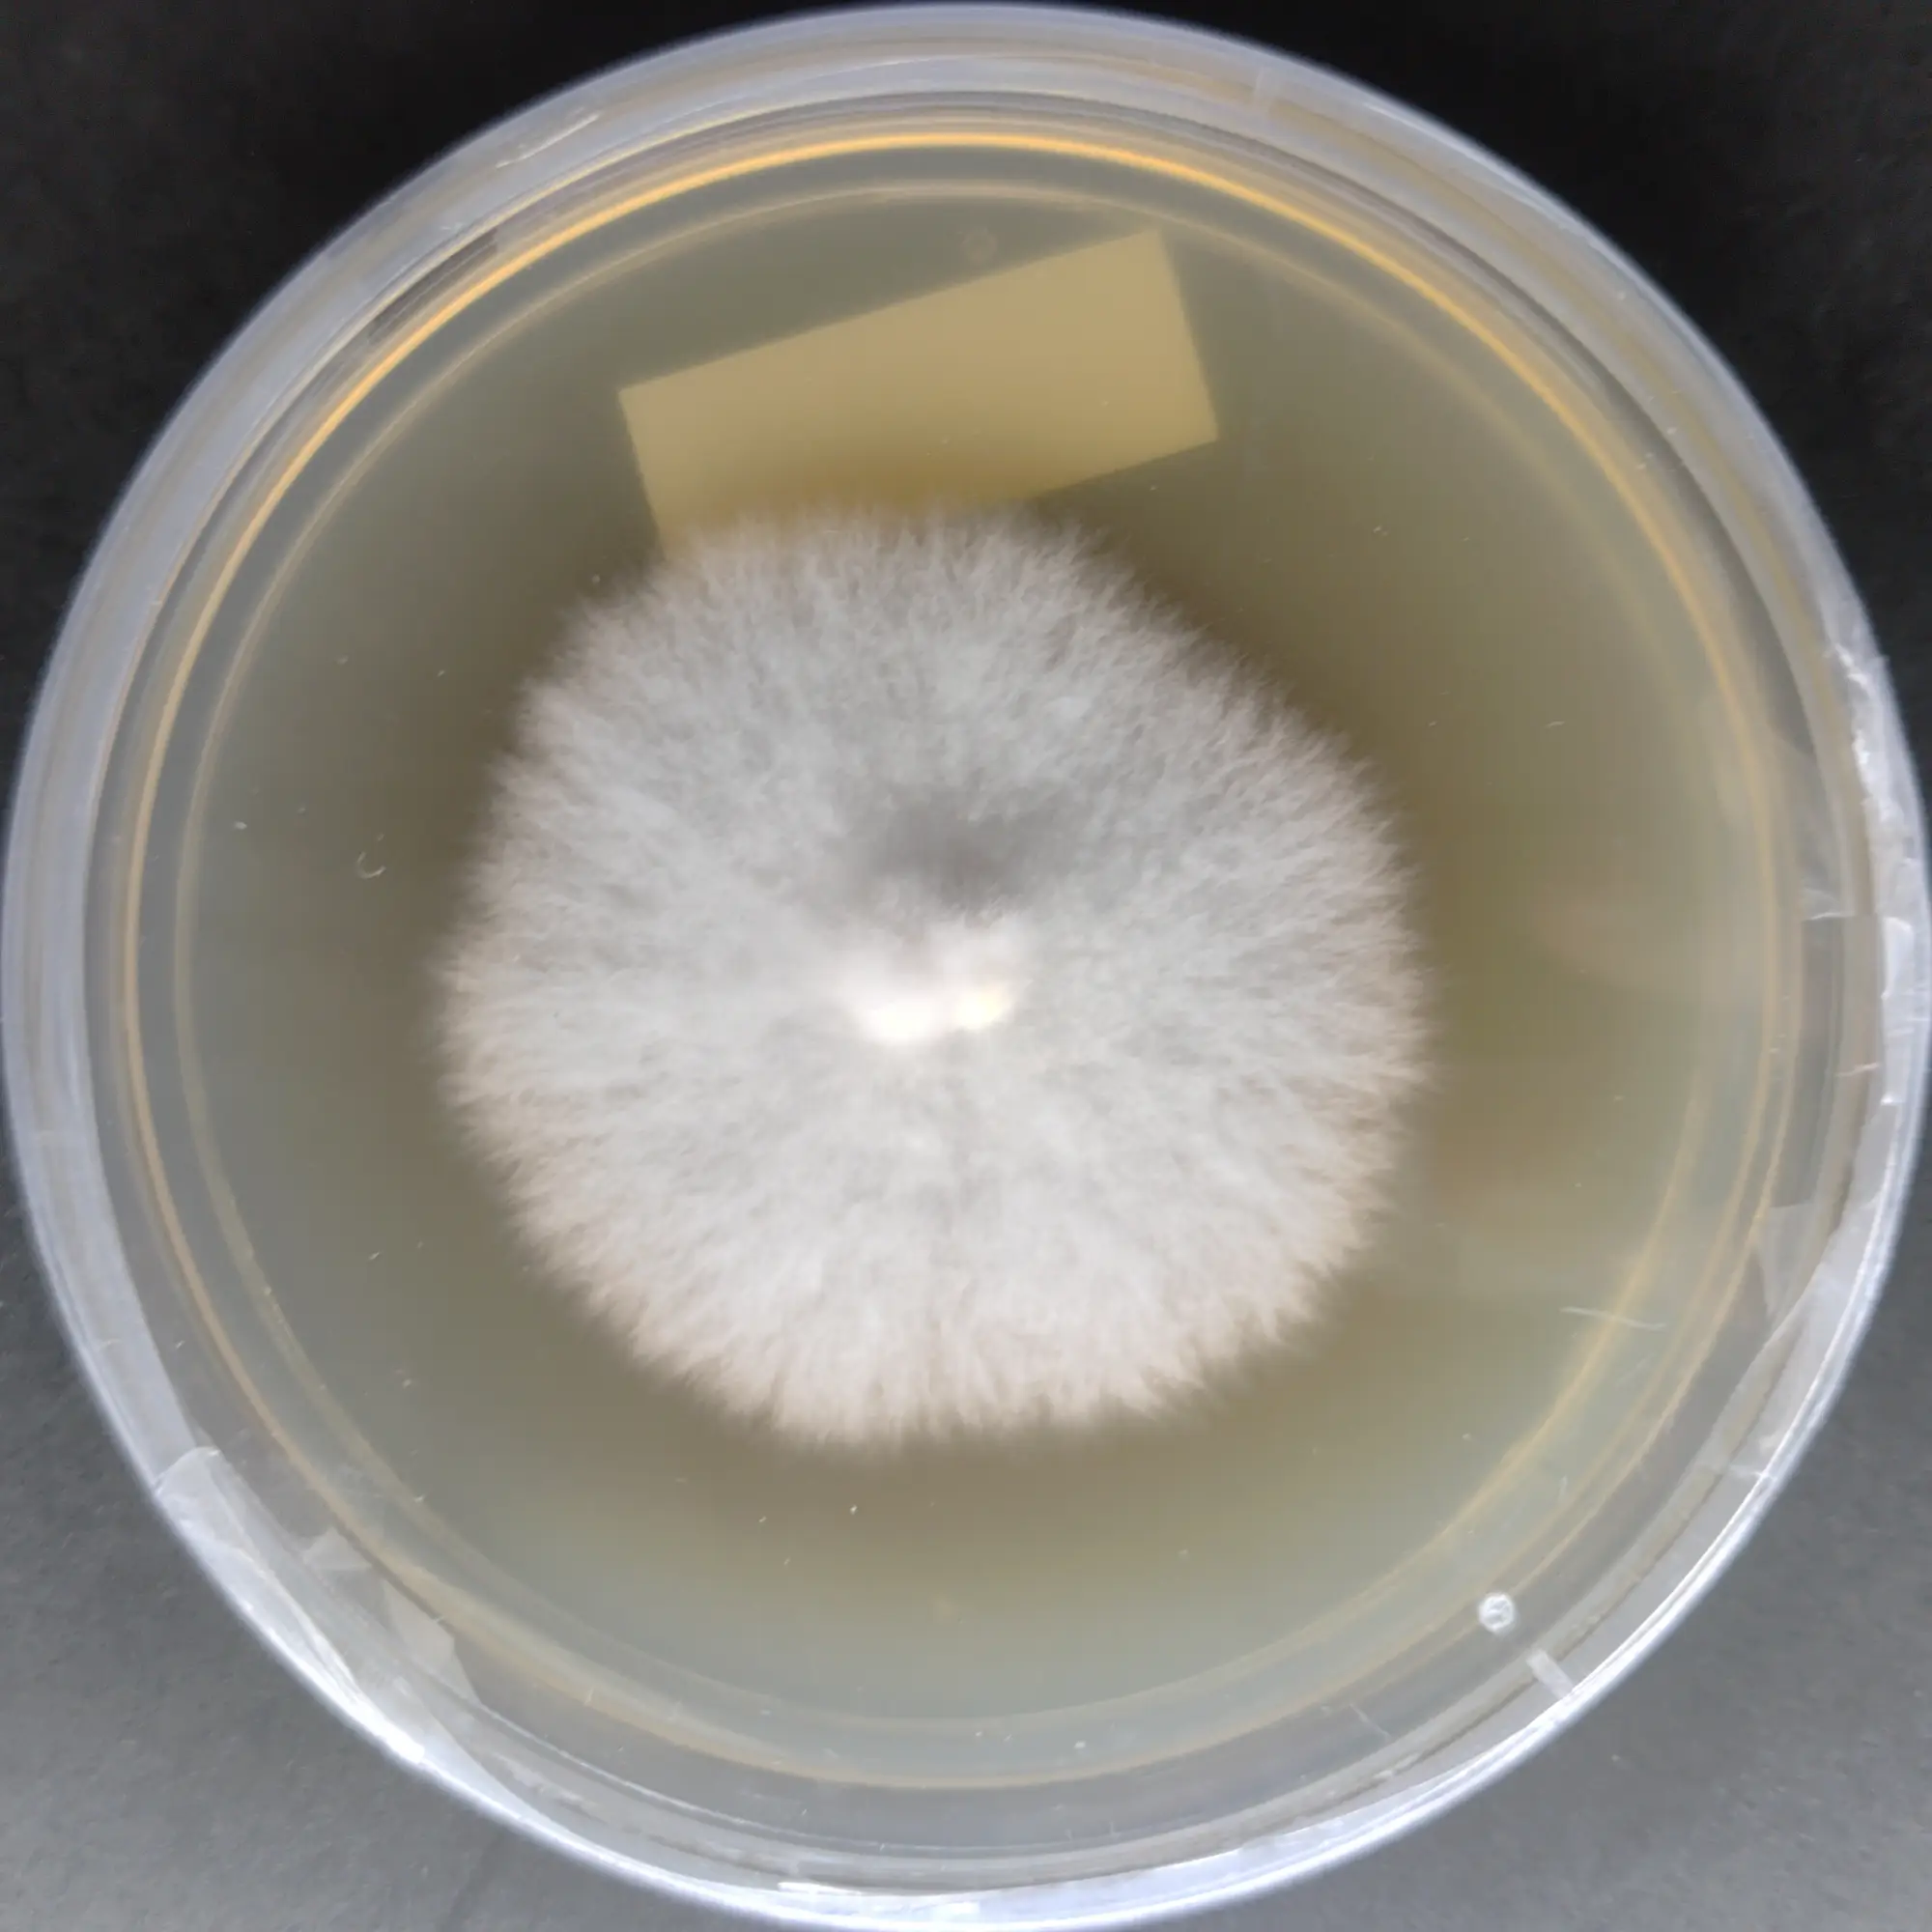
F107 Macrocybe gigantea.webp

Macrocybe gigantea culture plate (dried milk mushroom)
Macrocybe giganteum (Giant Mushroom) agar culture
Maitake mushroom culture (Grifola frondosa)
MUHSROOM CULTURE BANK PURE CULTURE - MEDICINAL MUSHROOMS PURE CULTURE - SPECIALTY MUSHROOMS All Products